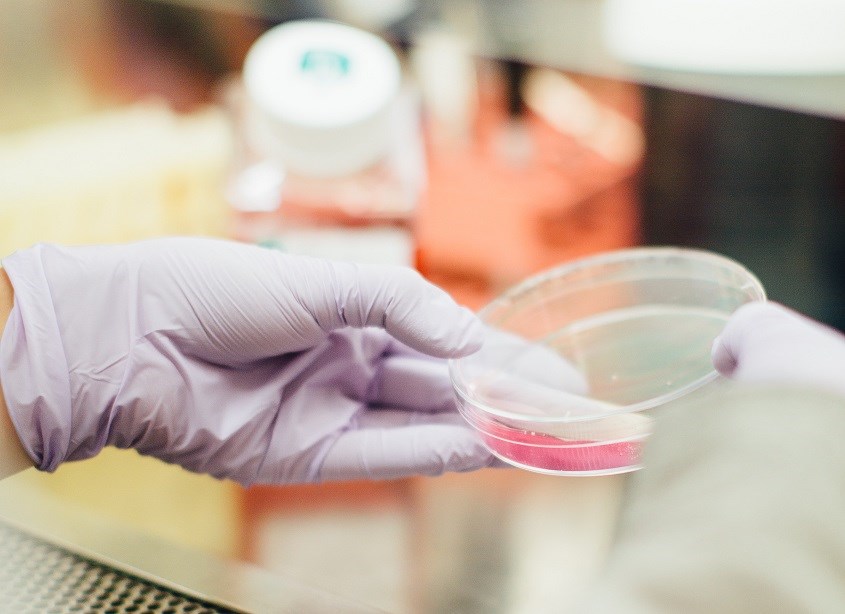
Xét nghiệm sàng lọc sơ sinh giúp phát hiện sớm dị tật bẩm sinh ở trẻ

Xét nghiệm sàng lọc sơ sinh giúp phát hiện sớm dị tật bẩm sinh ở trẻ.
Sàng lọc sơ sinh bao gồm chương trình thăm khám tổng quát và thực hiện một số xét nghiệm cho trẻ sơ sinh. Mục đích của xét nghiệm sàng lọc sơ sinh là giúp phát hiện sớm các bệnh lý, dị tật bẩm sinh hay rối loạn tiềm ẩn có thể đe dọa tính mạng và ảnh hưởng đến sức khỏe của em bé.
Tại các cơ sở y tế, xét nghiệm sàng lọc sơ sinh thường diễn ra tuần tự theo các bước sau:
Bước đầu sau sinh, bác sĩ hoặc các nhân viên y tế sẽ tiến hành thăm khám tổng quát cho trẻ. Qua đó, các dị tật bẩm sinh liên quan đến hình thể như hở hàm ếch, tật bàn chân khoèo, trật khớp háng,… sẽ được phát hiện từ sớm và đưa ra các biện pháp điều trị kịp thời.
Theo các chuyên gia, khoảng 48 – 72 giờ sau sinh là thời điểm phù hợp để lấy máu. Để thực hiện xét nghiệm sàng lọc sơ sinh, nhân viên y tế sẽ lấy máu tĩnh mạch hoặc vài giọt máu ở gót chân của bé. Hiện tại, phương pháp lấy máu gót chân sàng lọc sơ sinh đang được sử dụng phổ biến do vị trí này có lượng máu khá dồi dào, đủ lượng cần thiết cho yêu cầu xét nghiệm. Hơn nữa, vùng gót chân kém nhạy cảm hơn so với các bộ phận khác nên khi chích lấy máu sẽ ít gây đau đớn cho bé.
Phương pháp lấy máu gót chân sàng lọc sơ sinh đang được sử dụng phổ biến. Nguồn: Unsplash
Sau khi lấy 1 - 2 giọt máu ở gót chân trẻ cho vào giấy thấm, để khô, nhân viên y tế sẽ tiến hành xét nghiệm mẫu máu. Thời gian trả kết quả sẽ tùy số lượng bệnh cha mẹ muốn tầm soát, thường sẽ tầm 10 – 15 ngày.
Với trường hợp trẻ xuất viện sớm, việc lấy máu có thể sẽ được thực hiện sớm hơn, tuy nhiên sau đó cần kiểm tra lại lần 2 để đảm bảo kết quả chính xác. Còn với trẻ sinh non vẫn có thể lấy mẫu xét nghiệm, tuy nhiên cần tái kiểm tra và thời gian thu mẫu lặp lại được chỉ định cụ thể cho từng trường hợp.
Bên cạnh lấy máu gót chân sàng lọc sơ sinh, các cơ sở y tế còn thực hiện các kiểm tra khác như:
Ngoài ra, khi đọc kết quả sàng lọc sơ sinh phát hiện điều bất thường, bác sĩ sẽ chỉ định làm thêm một số xét nghiệm chuyên sâu để giúp chẩn đoán bệnh chính xác hơn.
Xét nghiệm sàng lọc sơ sinh được thực hiện để tầm soát các bệnh lý liên quan đến các rối loạn chuyển hóa, bệnh lý khiếm thính bẩm sinh, hay các bệnh lý tim bẩm sinh,… Thông thường, các bậc phụ huynh sẽ xét nghiệm sàng lọc sơ sinh 5 bệnh sau:
Suy giáp bẩm sinh (CH) ở trẻ
Tuyến giáp nằm phía trước cổ, là tuyến nội tiết có vai trò quan trọng giúp điều hòa sự phát triển, thúc đẩy sự hoạt động và trưởng thành của tế bào. Suy giáp bẩm sinh (CH) là loại bệnh lý gây chậm phát triển tinh thần vận động. Bệnh này sẽ khiến trẻ bị lùn và đần độn do sự thiếu hụt hormone tuyến giáp. Đây là hormone có vai trò quan trọng cho sự phát triển thể chất và trí tuệ của trẻ.
Tình trạng rối loạn nội tiết dẫn đến tăng hoặc giảm hormone của cơ thể trẻ, ảnh hưởng đến sự phát triển và để lại di chứng cả đời. Nếu được phát hiện và điều trị sớm trong khoảng 2 - 3 tuần đầu sau sinh, trẻ vẫn có thể khỏe mạnh và phát triển bình thường.
Tăng sản tuyến thượng thận bẩm sinh (CAH) là loại bệnh lý có tính di truyền, gây bất thường bộ phận sinh dục và rối loạn điện giải đồ ở trẻ. Nguyên nhân của bệnh CAH là do rối loạn sản xuất các hormone của tuyến thượng thận.
Ngoài ra, bệnh tăng sản tuyến thượng thận gây rối loạn nước điện giải có thể khiến bé gái có bộ phận sinh dục dần phát triển nam tính, do tuyến thượng thận sản sinh ra androgen, dậy thì sớm, hay thậm chí là tử vong.
Bệnh Phenylketone niệu (PKU) là một dạng rối loạn gây tích tụ axit amin phenylalanine, một axit amin thiết yếu cơ thể không thể tự tổng hợp nhưng có sẵn trong thức ăn. Loại bệnh này sẽ dẫn đến bệnh da Eczema, gây suy hô hấp, co giật, nghiêm trọng hơn là tử vong. Khi lớn hơn, trẻ rơi vào tình trạng chậm phát triển thể chất và trí tuệ.
Bệnh Phenylketone niệu (PKU) sẽ dẫn đến bệnh da Eczema ở trẻ
Trẻ sơ sinh mắc bệnh này hiếm khi biểu hiện các triệu chứng ngay. Tuy nhiên vẫn một số dấu hiệu mà cha mẹ có thể lưu ý như:
Cần thực hiện xét nghiệm sàng lọc sơ sinh để phát hiện bệnh PKU sớm, từ đó có hướng điều trị kịp thời và chế độ ăn uống hợp lý.
Rối loạn chuyển hóa đường Galactose là một dạng rối loạn di truyền, hay cụ thể là rối loạn gen lặn trên NST. Bệnh này sẽ khiến trẻ thiếu hụt vài loại enzyme cần thiết cho sự chuyển hóa đường Galactose (có trong sữa công thức, các chế phẩm từ sữa, kể cả sữa mẹ) thành đường Glucose - loại đường giúp cung cấp năng lượng cho cơ thể.
Khi bị rối loạn chuyển hóa, đường Galactose sẽ tích tụ dần trong cơ thể trẻ và trở thành độc tố gây tổn thương nghiêm trọng nội tạng.
Thiếu men G6PD là một loại bệnh di truyền, xảy ra do sự rối loạn liên quan đến hemoglobin trong hồng cầu. Khi mắc bệnh sẽ gây tình trạng thiếu máu và vàng da ở trẻ sơ sinh. Nguyên nhân bệnh này do cơ thể trẻ thiếu G6PD, một loại enzym có vai trò quan trọng giúp màng tế bào hồng cầu bền vững trước các tác nhân oxy hóa. Thiếu men G6PD sẽ khiến hồng cầu kém ổn định và dễ bị vỡ bởi các tác nhân oxy hóa.
Nếu không điều trị kịp thời, trẻ có thể bị tổn thương não và để lại di chứng nặng nề như chậm phát triển trí tuệ, thần kinh vận động và cả thể chất.
Hiện tại, các xét nghiệm sàng lọc sơ sinh ngày càng đa dạng nhờ vào sự tiến bộ khoa học kỹ thuật. Bên cạnh các xét nghiệm sàng lọc sơ sinh thường quy, cơ sở y tế còn tầm soát một số loại bệnh khác như:
Bệnh xảy ra khi cơ quan thính giác bị tổn thương ngay từ trong bụng mẹ hoặc trong lúc sinh nở. Thính lực suy giảm sẽ khiến trẻ chậm nói, chậm phát triển trí não và ảnh hưởng nghiêm trọng đến quá trình nhận thức về sau. Sàng lọc sơ sinh sẽ giúp sớm phát hiện nếu trẻ bị suy giảm thính lực bẩm sinh và có cách điều trị kịp thời.
Những trẻ mắc bệnh tim bẩm sinh cũng khó thấy điều bất thường thông qua lâm sàng ngay sau khi sinh kể cả trường hợp nặng. Việc phát hiện sớm các tật tim bẩm sinh thông qua sàng lọc sơ sinh trong vài ngày đầu sẽ giúp giảm tỷ lệ bệnh tật cũng như đột tử do nguyên nhân tim mạch ở trẻ.
- Rối loạn chuyển hóa axit béo gây ra các vấn đề sức khỏe nghiêm trọng cho trẻ như rối loạn trương lực cơ, hôn mê, lơ mơ, co giật, thậm chí tử vong.
- Rối loạn chuyển hóa axit hữu cơ gây tổn thương não, các vấn đề về mắt và thị lực; chậm phát triển trí tuệ và thể chất; ảnh hưởng đến tim, gan, thận, tuyến tụy; tai biến, hôn mê,… thậm chí tử vong.
Gồm 2 loại chính:
- Bệnh tan máu bẩm sinh Thalassemia
- Các biến thể Hemoglobin như HbE, HbD, HbS, HbC, Hb SC,…
Trong đó, bệnh Thalassemia là căn bệnh khó điều trị nhưng lại dễ phòng ngừa thông qua xét nghiệm sàng lọc sơ sinh.
Tùy mỗi cơ sở y tế sẽ cung cấp các gói sàng lọc sơ sinh khác nhau, dao động từ trên dưới 300.000 VNĐ - 2.000.000 VNĐ và tuỳ số lượng bệnh cha mẹ muốn sàng lọc. Ví dụ: mỗi cơ sở y tế sẽ có gói kiểm tra 2 bệnh, gói sàng lọc sơ sinh 5 bệnh hoặc gói xét nghiệm 55 bệnh lý.
Do chi phí không quá đắt đỏ, cha mẹ có thể dễ dàng làm sàng lọc sơ sinh mà không phải lăn tăn quá nhiều về tài chính.
Tất cả các bé sau khi chào đời cần thực hiện xét nghiệm sàng lọc sơ sinh từ đơn giản đến chuyên sâu để tầm soát những nguy cơ tiềm ẩn về sức khỏe không biểu hiện rõ rệt qua lâm sàng. Nếu bệnh được phát hiện sớm và điều trị kịp thời, trẻ sẽ thêm nhiều cơ hội phát triển toàn diện, tránh được những mối nguy hiểm có thể khiến bé bị khuyết tật hoặc tử vong.
AVAKids mong rằng bài viết trên đã cung cấp đầy đủ thông tin cần thiết để các bậc phụ huynh tham khảo và cân nhắc thực hiện những xét nghiệm cần thiết cho con.
Tổng hợp bởi Ngọc Tú
Bài viết có hữu ích với bạn không?
Có
Không
Cám ơn bạn đã phản hồi!